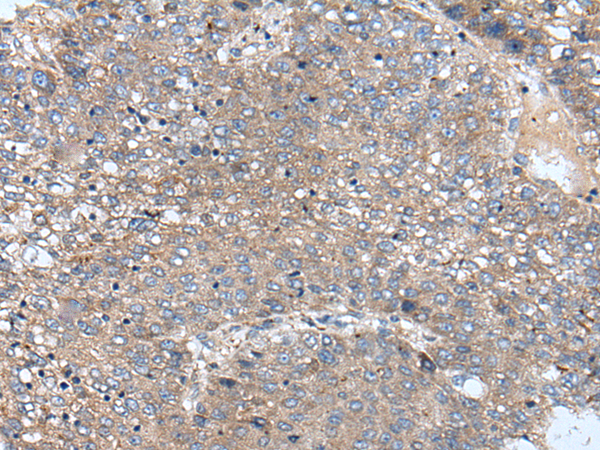

中文名稱:兔抗BICD1多克隆抗體
|
Background: |
This gene encodes an adaptor protein that belongs to the bicaudal D family of dynein cargo adaptors. The encoded protein acts as an intracellular cargo transport cofactor that regulates the microtubule-based loading of cargo onto the dynein motor complex. It also controls dynein motor activity and coordination. It has a domain architecture consisting of coiled-coil domains at the N- and C-termini that are highly conserved in other family members. Naturally occurring mutations in this gene are associated with short telomere length and emphysema. |
|
Applications: |
ELISA, IHC |
|
Name of antibody: |
BICD1 |
|
Immunogen: |
Synthetic peptide of human BICD1 |
|
Full name: |
BICD cargo adaptor 1 |
|
Synonyms: |
BICD; bic-D 1 |
|
SwissProt: |
Q96G01 |
|
ELISA Recommended dilution: |
5000-10000 |
|
IHC positive control: |
Human liver cancer |
|
IHC Recommend dilution: |
20-100 |
購物車
幫助
021-54845833/15800441009
